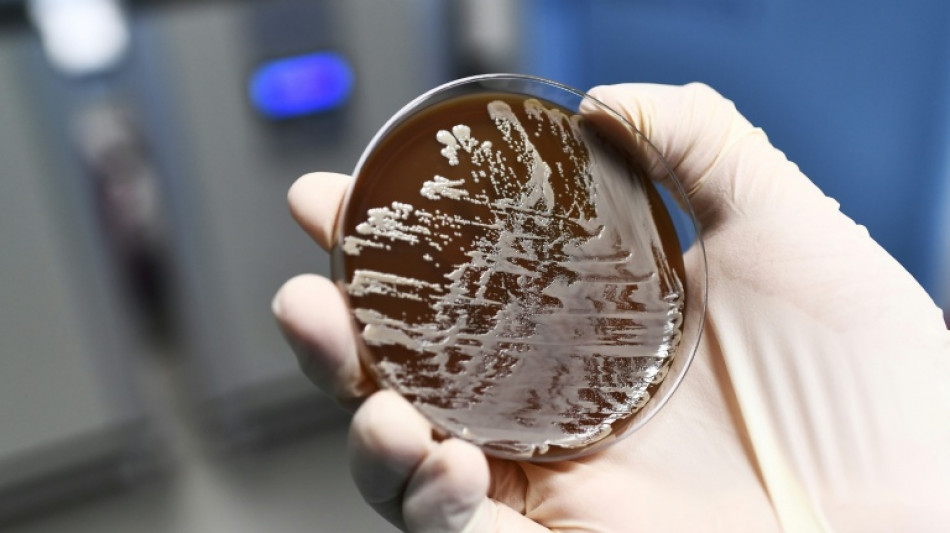
RKI: 9600 Menschen durch antibiotikaresistente Erreger gestorben

RKI: 9600 Menschen durch antibiotikaresistente Erreger gestorben
Im Jahr 2019 sind einer Schätzung des Robert Koch-Instituts (RKI) zufolge in Deutschland 9600 Menschen durch antibiotikaresistente Erreger gestorben. Diese Betroffenen seien unmittelbar aufgrund der Resistenz des Erregers gestorben, teilte das RKI am Dienstag in Berlin mit. Wären die Betroffenen demnach mit dem gleichen Erreger ohne Antibiotikaresistenz infiziert gewesen, hätten sie vermutlich ihre Infektion überlebt.
Insgesamt starben nach der Auswertung 2019 sogar 45.700 Menschen im Zusammenhang mit antibiotikaresistenten Infektionen. Die Infektion mit einem antibiotikaresistenten Erreger war zwar Todesursache in dieser größeren Zahl der Fälle. Die Betroffenen wären demnach aber vermutlich auch dann gestorben, wenn der Erreger keine Resistenz aufgewiesen hätte.
Grund für die meisten Todesfälle war, dass sich die Infektionen im Blut, in den Atemwegen oder im Bauchraum befanden. Ein Großteil der Todesfälle, die im Zusammenhang mit antibiotikaresistenten Errgern stehen, ging auf fünf Bakterienarten zurück - darunter das Kolibakterium Escherichia coli, kurz: E. coli.
Das RKI arbeitete für die Schätzung mit dem Institute for Health Metrics and Evaluation (IHME) der Universität Washington zusammen. Es handle sich um die bislang umfassendsten Schätzungen zur Krankheitslast durch Antibiotikaresistenz in Deutschland vor der Coronapandemie.
S.Esposito--LDdC



